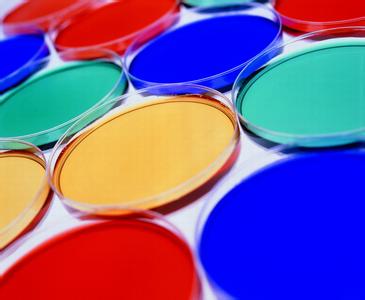
涂料助劑

不同的涂料助劑具體起到什么作用呢?
涂料助劑是涂料原料之一,少量加入即可大幅度提高涂料的功效和性能。還能改善涂膜性能,有助于實(shí)現(xiàn)產(chǎn)品的個(gè)性化。涂料助劑應(yīng)具備各種不同的性能和功效,那不同的涂料助劑具體起到什么作用呢?
一、按用途分類:
①有些助劑是在涂料制造時(shí)發(fā)揮作用:如分散劑,消泡劑、脫泡劑、乳化劑、催化劑等;
②有些助劑是在涂料貯存時(shí)發(fā)揮作用:如增稠劑、防沉劑、防腐劑、防銹劑等; 涂料在生產(chǎn)階段中處于高剪切力狀態(tài),而在貯存階段已經(jīng)沒有了剪切力,這時(shí)顏填料就容易絮凝、返粗、沉淀等不良現(xiàn)象,這時(shí)便需要此類助劑來發(fā)揮作用。
③有些助劑是在漆膜干燥時(shí)(施工時(shí))發(fā)揮作用:如流平劑、防流掛劑、密著劑、基材潤濕劑、催干劑、固化劑等。
二、按起作用的位置和方式分:
①表面活性劑:這類助劑擁有吸附基,能在界面或接近界面的位置發(fā)揮作用,如潤濕分散劑、流平劑、乳化劑、防沉劑、消泡劑、表面處理劑等;
②非表面活性劑:這類助劑為了增強(qiáng)涂料漆膜某個(gè)或某些性能而在涂膜中發(fā)揮作用的,如導(dǎo)電劑、阻燃劑、增稠劑、固化劑、防沉劑、防腐劑、消光劑、增塑劑等;
每個(gè)涂料助劑都有其特殊的作用,但有時(shí)當(dāng)兩種或多種涂料助劑添加在一起時(shí),他們有時(shí)會(huì)出現(xiàn)“拆臺”的現(xiàn)象,這時(shí)就需要注意助劑之間的平衡性了,只有通過多種添加比例的實(shí)驗(yàn),才能找出各種助劑在配方中發(fā)揮大的功效。
此文關(guān)鍵字:涂料助劑
同類文章排行
- 絲印油墨的消泡與脫泡問題
- 水性柔板和凹版油墨,上光油消泡劑問題
- 迪高消泡劑常見問題
- 消泡劑是如何起作用的?
- 脂方族水性樹脂,有什么特殊性能?
- 醇溶性聚氨酯樹脂與水性聚氨酯樹脂有什么區(qū)別
- 水性樹脂為什么對鋁的附著力不好,怎么解決
- 分散高色素炭黑和普通炭黑要用不同的分散劑
- 分散劑分散鈦白粉炭黑彩色為什么效果不一樣
- 加消光粉后涂料表面顆粒感產(chǎn)生原因及解決方法
最新資訊文章
- 具有隔熱反射功能涂料的制備方法
- 雙組份透明玻璃隔熱涂料配方及其制備方法
- 自清潔有機(jī)硅改性丙烯酸樹脂隔熱反射涂料制備方法
- 復(fù)合型水性丙烯酸隔熱涂料及其制備方法
- 高固含量水性紫外光固化透明隔熱涂料及其制備方法
- 環(huán)保型透明隔熱涂料配方及其制備方法
- 納米ATO/TiO2填料水性聚氨酯隔熱透明涂料配方
- 合成聚氨酯玻璃隔熱涂料配方及其制備方法
- 環(huán)保隔熱涂料及其制備方法
- 防水隔熱外墻涂料配方及其制備方法
您的瀏覽歷史






